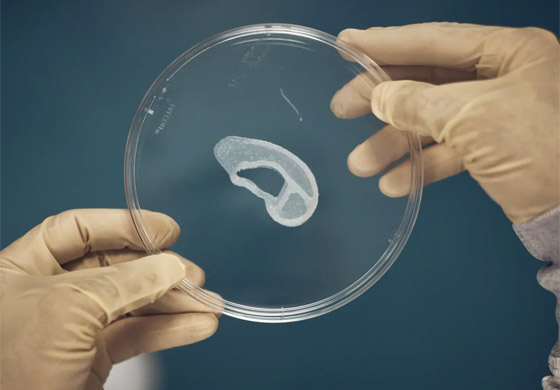
الأولى من نوعها.. عملية زرع أذن مطبوعة لكنها

في إنجاز طبي من شأنه مساعدة الأشخاص الذين يعانون عيبا خلقيا نادرا، أجرى فريق طبي أميركي عملية زرع هي الأولى من نوعها لأذن بشرية أُنشئت من خلايا المريض المعالج، باستخدام طابعة ثلاثية الأبعاد. وأجريت العملية في إطار تجربة سريرية لتقييم مدى توافر السلامة في اللجوء إلى هذه الغرسة ودرجة فاعليتها للأشخاص الذين يعانون صغر الأذن، والذين لم تنمُ أذنهم الخارجية بشكل صحيح.
وتحمل الغرسة اسم "أورينوفو" وابتكرتها شركة "ثري دي بايو ثيرابوتيكس"، فيما نفذ العملية أرتورو بونيا، وهو مؤسس معهد متخصص في علاج هذا التشوه في سان أنطونيو بولاية تكساس الأميركية. ونقل بيان للشركة عن الجراح قوله: "كطبيب عالج آلاف الأطفال الذين يعانون صغر الأذن في أنحاء البلد وحول العالم، أنا متحمس لهذه التقنية وما يمكن أن تعنيه للمرضى وعائلاتهم".

ويتم تنفيذ العملية عن طريق تكوين انطباع ثلاثي الأبعاد لأذن المريض الأخرى النامية بالكامل ثم جمع خلايا غضاريف أذنه. ثم يتم استزراع هذه الغضاريف للحصول على كمية كافية منها، ثم تخلط مع هيدروجيل الكولاجين، الذي يستخدم لطباعة الزرع. وتُحاط الغرسة بقشرة مطبوعة قابلة للتحلل لدعمها، ويمتصها جسم المريض بمرور الوقت.
ويُفترض بالأذن المزروعة أن توفّر بمرور الوقت شكل أذن طبيعية وملمسها ومرونتها. ويبلغ إجمالي عدد المرضى الذين يتوقع أن تشملهم التجربة السريرية 11 شخصا في ولايتي كاليفورنيا وتكساس. وأمل الدكتور بونيا في أن تحل الغرسة يوما ما محل العلاجات الحالية والتي تقوم على إنشاء طرف اصطناعي عبر إزالة الغضروف من الضلع، أو مادة تسمى البولي إيثيلين المسامي.
استخدامات مختلفة
ووفق شركة "ثري دي بايو ثيرابوتيكس"، فإن صغر الأذن يطال سنويا نحو 1500 طفل في الولايات المتحدة لوحدها. ويمكن لهؤلاء الأطفال أن يعيشوا بشكل طبيعي ما لم تكن لديهم مشاكل صحية أخرى، غير إن بعضهم قد يتأثر سلبا بنظرة الآخرين إلى هذا التشوه. وتشمل العوامل التي قد تزيد من خطر الإصابة بتشوّه صيوان الأذن، إصابة الأم بمرض السكري أو اتباعها نظاما غذائيا لا يتوافر فيه قدر كاف من الكربوهيدرات وحمض الفوليك.
وتطمح الشركة إلى أن تبتكر مستقبلا غرسات لأشكال أكثر شدة من صغر الأذن، علما أنه يمكن استخدام الغرسات الثلاثية الأبعاد في حالات أخرى تطال الغضروف، منها العيوب أو الإصابات في الأنف، أو إعادة بناء الثدي، أو تلف الغضروف المفصلي في الركبة.




